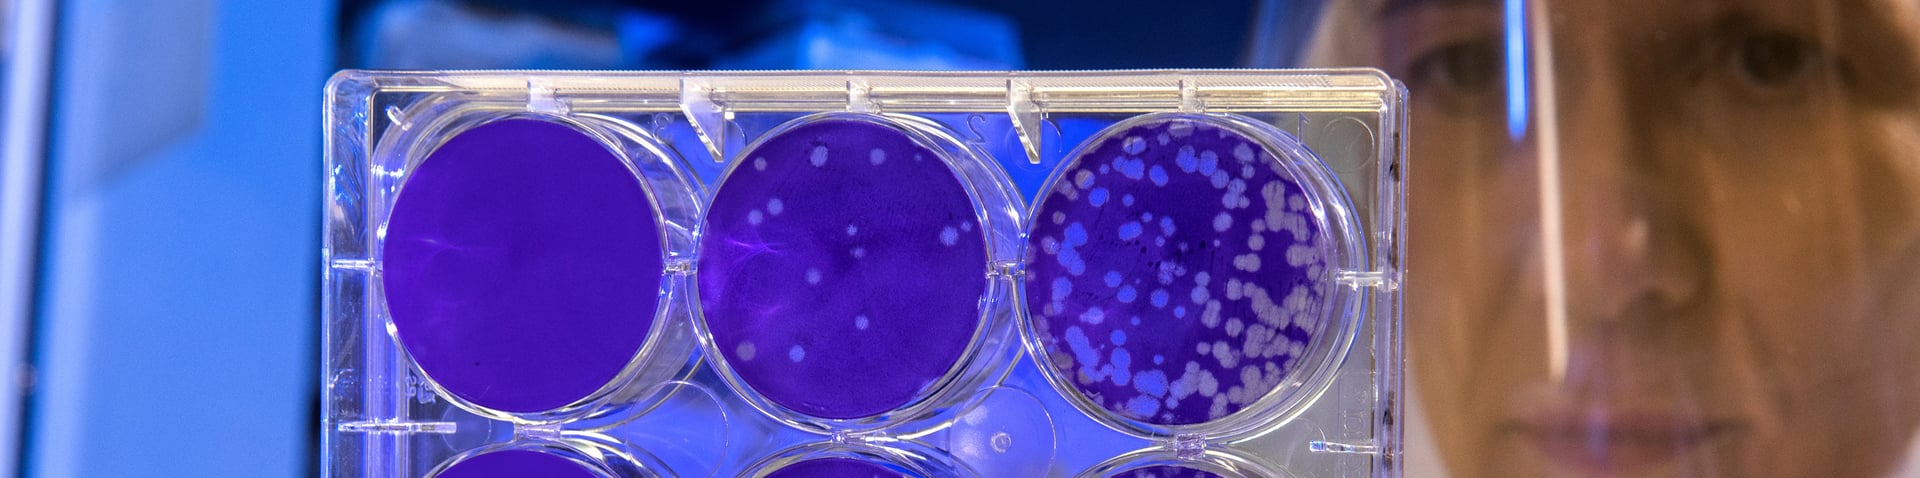

Navigating a Home Transaction with a Pandemic Looming
With the coronavirus spreading rapidly across the globe, including several cases confirmed in the Bay Area, with an increasing number of places across the U.S., we are preparing for an impact on East Bay real estate as the spring selling season rapidly approaches.
Already at Red Oak we’ve had one transaction directly impacted by the coronavirus. Red Oak agent Gabriela Neagu represented a buyer who went under contract on a condo on Jan. 25 with a 21-day close.
Soon after going under contract, she and the buyer discovered the seller was in Wuhan, China, epicenter of the outbreak. Trapped in quarantine, the seller can’t get back to execute the close and has agreed to contingencies related to the hiccup -- including paying for an extension of the buyer’s 30-day mortgage rate lock and an agreement to pay for the home inspection and appraisal if he wasn’t able to get back to the U.S. in time to close and the transaction fell through. The seller made it back to the U.S., and the deal’s still active.
As the virus deepens and spreads in the U.S., East Bay buyers and sellers will increasingly have to account for the coronavirus in their plans.
Here are some tips to best navigate buying and selling during this uncertain time.
Navigating a Home Transaction with a Pandemic Looming
First of all, if you’re planning on traveling, anywhere, while under contract on a home as a buyer or a seller, grant someone locally in the East Bay the power of attorney to complete the transaction should you be detained somewhere else.
A quarantine can prevent designation of a power of attorney after the fact given you may be in separate locations. Indeed, this happened in the transaction above. The parties discussed notarizing a local power of attorney but could not execute it because of the quarantine.
Reach out to a Red Oak Realty agent for perspective on transacting in a coronavirus reality and to coordinate a power of attorney if you need one.
Other Smart Ways to Prepare
Red Oak has put together a detailed company policy regarding how agents should prepare and account for the effects of the coronavirus on their transactions. We outline some of these below.
Buyers, especially those with down payment funds contingent on the stock market, should work with their agents to put contingencies into their offers that allow them to back out if they can’t move forward should stock market declines preclude them from performing. A specialized contingency in place will ensure they get their earnest money back in these cases.
Be careful about visiting open houses. The more exposure to areas where many people travel, the higher the risk for catching something, whether it be the coronavirus or another germ.
Also, if transacting, make sure that your agent has a back-up plan should they become ill while under contract. Many responsible agents have colleagues to support them, but it’s wise to be explicitly on the same page with your agent here.
Prepare for a Dampened Selling Season
Many buyers, especially in the East Bay given the high concentration of area tech employees, rely on money tied in the stock market for down payments and all cash offers.
The stock market, of course, has experienced a large tumult based on uncertainty related to the coronavirus. Buyers who were planning to purchase this spring and have down payment funds tied into the stock market, may have to reassess their plans. Keeping a financing contingency in place that is tied to this issue could prevent the loss of good faith earnest money should a buyer need to cancel a transaction due to a market decline.
Sellers should prepare for an unpredictable market, and potentially dampened demand as buyers face challenges in accessing down payment funds tied to the stock market or simply get cold feet with the economic volatility. Sellers should be aware of some uncertainty related to this and prepare for buyer escape clauses that give them an out if stock market tumbles block their ability to perform. Ultimately, however, they should not panic about a massive decline in prices.
The Potential Upside
But it’s certainly not all doom and gloom. Pulling money out of the stock market and investing it into real estate may be a wise decision as the markets face volatility related to the coronavirus uncertainty.
Also, if you’ve moved money out of the stock market already, or are planning to, real estate, especially, in the East Bay, offers investment stability few other vehicles offer.
In addition, with the interest rate drop this week, buyers can secure 30-year mortgages at a rate potentially below 3 percent. That could save buyers approximately 10 percent over the life of a 30-year loan compared to a 4 percent rate. The normal hot spring market could be cooler than usual as buyers wait and see and act this summer once things settle down.
Buyers and homeowners alike should keep in mind that the outbreak in China in addition to the trade tariffs will most likely continue to affect housing construction materials, so renovations will likely become more expensive as those costs rise over the next several months.
Everyone’s situation is unique and a strategic plan during this time should be discussed using a holistic approach with an agent. Reach out to a Red Oak Realty agent to discuss the smartest way for you to buy or sell in this uncertain time.





